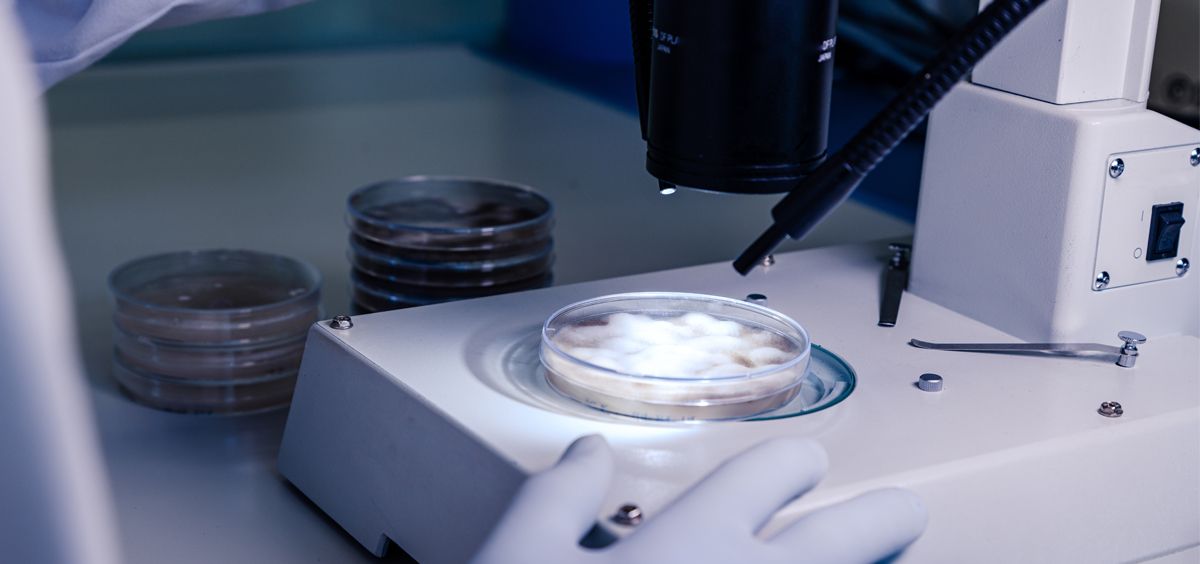
SaluDigital tweet media

❓Una revisión concluye que, en la atresia biliar, la cirugía temprana puede restablecer el flujo biliar, pero no siempre evita el daño hepático a largo plazo
👉 El estudio advierte de que muchos #pacientes siguen desarrollando fibrosis y #cirrosis
consalud.es/saludigital/ia…

Español